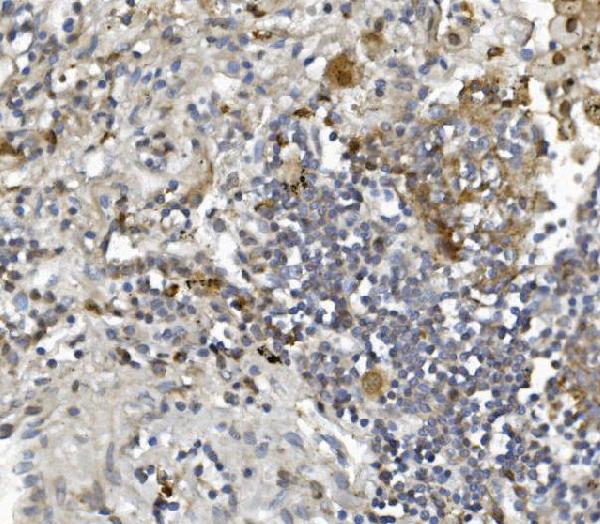

Filters
Clonality
Type
Reactivity
Gene Name
Isotype
Host
Application
Clone
1194 results for " E" - showing 1000-1050
Rad9/Rad9a, Polyclonal Antibody (Cat# AAA19288)
AGO3, Polyclonal Antibody (Cat# AAA19290)
PDE6 alpha/PDE6A, Polyclonal Antibody (Cat# AAA19318)
Caspase-9/CASP9, Polyclonal Antibody (Cat# AAA19215)
Serum Response Factor/SRF, Polyclonal Antibody (Cat# AAA19221)
Caspase-7/CASP7, Polyclonal Antibody (Cat# AAA19232)
Prohibitin/PHB, Polyclonal Antibody (Cat# AAA19234)
GNG7, Polyclonal Antibody (Cat# AAA19335)
DDX1, Monoclonal Antibody (Cat# AAA19378)
PCK2, Monoclonal Antibody (Cat# AAA19384)
Aldolase/ALDOA, Monoclonal Antibody (Cat# AAA19385)
ch TOG/CKAP5, Monoclonal Antibody (Cat# AAA19386)
Acetyl-Histone H3, Polyclonal Antibody (Cat# AAA31057)
Galectin 9 (GAL9), Active Protein (Cat# AAA21103)
CD11b, Monoclonal Antibody (Cat# AAA12146)
PAK1, Polyclonal Antibody (Cat# AAA31096)
ATP citrate lyase, Polyclonal Antibody (Cat# AAA11689)
CD25, Monoclonal Antibody (Cat# AAA11966)
CD11b, Monoclonal Antibody (Cat# AAA11971)
MVP, Polyclonal Antibody (Cat# AAA19137)
Cyclin E1, Polyclonal Antibody (Cat# AAA31439)
Predicted Reactivity: Bovine (88%), Horse (88%), Sheep (88%), Chicken (88%), Xenopus (88%)
Histone H3, Polyclonal Antibody (Cat# AAA30929)
RGS6, Polyclonal Antibody (Cat# AAA19308)
GNG2, Polyclonal Antibody (Cat# AAA19312)
ETF/TEAD2, Polyclonal Antibody (Cat# AAA19325)
MCU, Polyclonal Antibody (Cat# AAA19226)
PCBP2/hnRNP E2, Polyclonal Antibody (Cat# AAA19259)
ATG9A, Polyclonal Antibody (Cat# AAA19280)
SHANK3, Polyclonal Antibody (Cat# AAA19237)
ALK-1/ACVRL1, Polyclonal Antibody (Cat# AAA19242)
TMPRSS3, Polyclonal Antibody (Cat# AAA19289)
MitoNEET/CISD1, Polyclonal Antibody (Cat# AAA19293)
ALDH1L1, Polyclonal Antibody (Cat# AAA19297)
Transketolase/TKT, Monoclonal Antibody (Cat# AAA19368)
TLR1, Polyclonal Antibody (Cat# AAA19134)
No cross reactivity with other proteins.
Flt3/CD135, Polyclonal Antibody (Cat# AAA19130)
No cross reactivity with other proteins.
beta Catenin, Polyclonal Antibody (Cat# AAA19129)
No cross reactivity with other proteins.
HP1 gamma, Polyclonal Antibody (Cat# AAA19145)
No cross reactivity with other proteins.
Cyclophilin B, Polyclonal Antibody (Cat# AAA19167)
No cross reactivity with other proteins.
NDEL1, Polyclonal Antibody (Cat# AAA31462)
Predicted Reactivity: Pig (100%), Bovine (100%), Horse (100%), Sheep (100%), Rabbit (100%), Dog (100%), Chicken (100%), Xenopus (100%)
CD11b, Monoclonal Antibody (Cat# AAA11876)
Histone H3, Polyclonal Antibody (Cat# AAA31095)
ERAB, Polyclonal Antibody (Cat# AAA11668)
Galectin 3 (GAL3), Active Protein (Cat# AAA21140)
TCP1 delta, Polyclonal Antibody (Cat# AAA11672)
No cross reactivity with other proteins.
p70 S6 Kinase, Polyclonal Antibody (Cat# AAA31408)
Predicted Reactivity: Pig (100%), Bovine (100%), Horse (100%), Sheep (100%), Rabbit (100%), Dog (100%), Chicken (100%), Xenopus (100%)
CD25, Monoclonal Antibody (Cat# AAA11965)
PDE4D, Polyclonal Antibody (Cat# AAA19143)
No cross reactivity with other proteins.
CD11b, Monoclonal Antibody (Cat# AAA11970)
MYLK, Polyclonal Antibody (Cat# AAA19154)
No cross reactivity with other proteins.